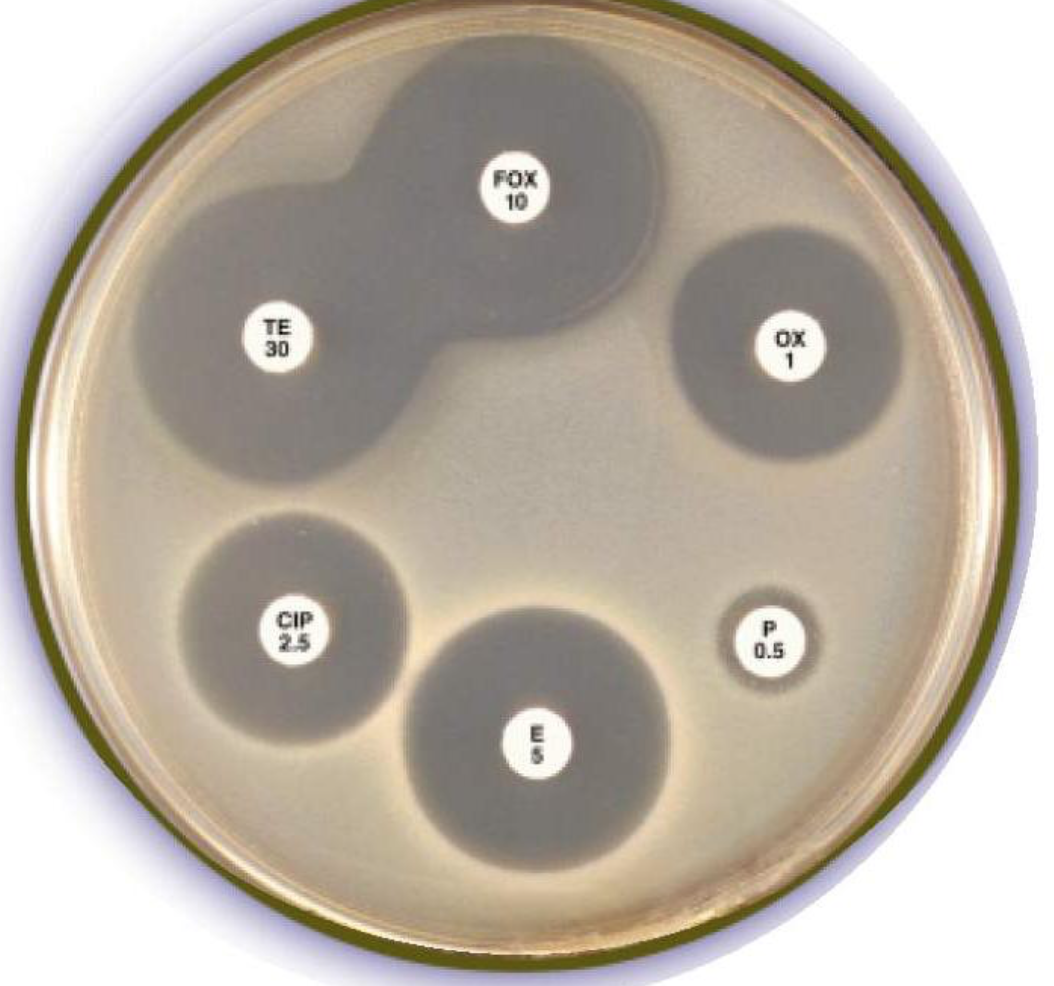
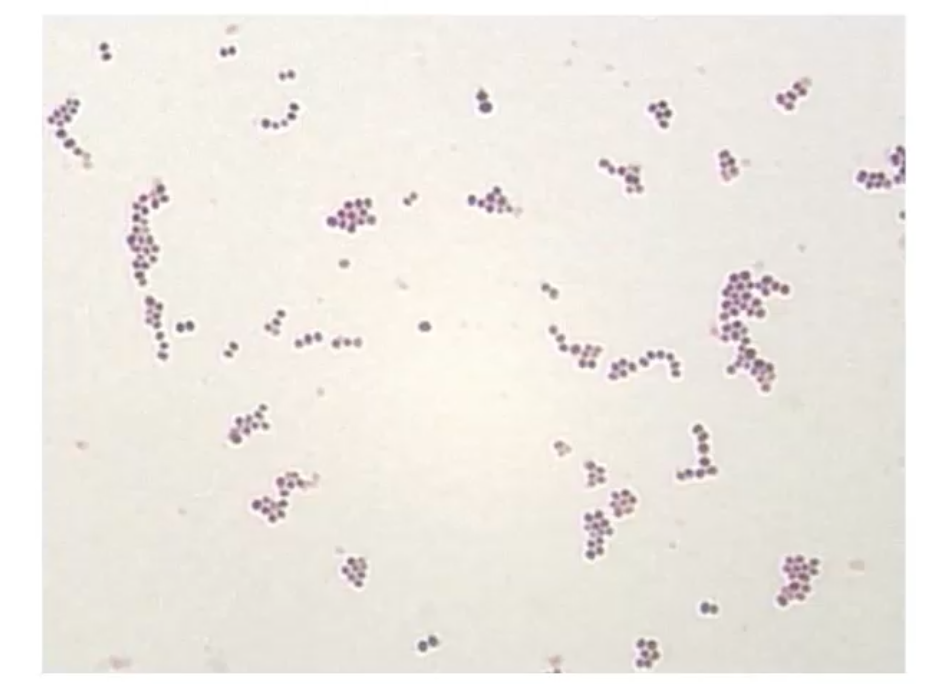
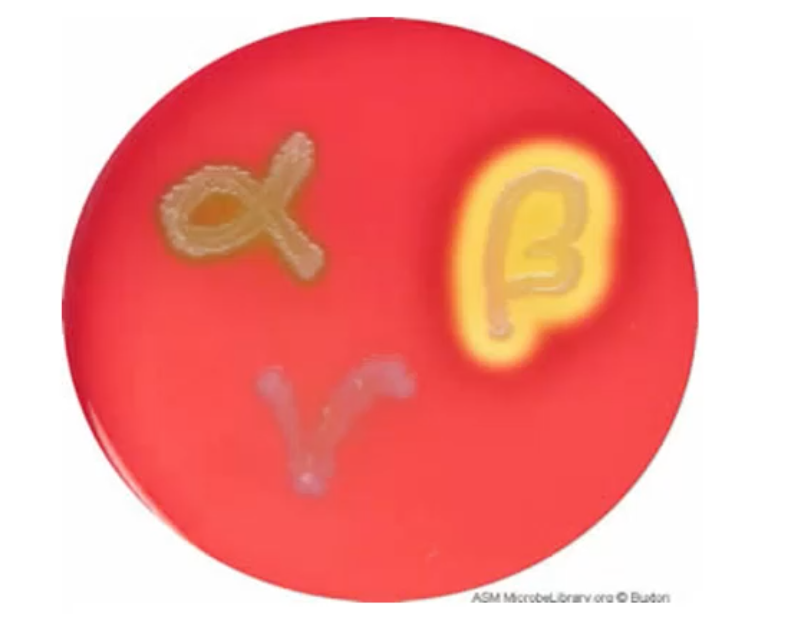

State some common diagnostic techniques used in a bacteriology lab.
Culture:
1) Sterile site (e.g blood/CSF) 2) Non-sterile sites
Can be used to amplify amount of bacteria for further testing.
Serology
Molecular techniques
Antibmicrobial sensitivity testing
What are molecular techniques used for?
Detect resistance genes
Alternatively do antimicrobial susceptibility testing but this takes a long time
Where are cultures extracted from to determine antimicrobial resistance?
Sterile sites e.g. blood and CSF
Non-sterile sites (difficult due to great numbers of bacteria)
What type of culture is found in the abdomen and urinary tract
gram -ve
Define serology.
Scientific study of bodily fluids (usually to detect presence of antiboides)
What is serology done for?
Determine body’s response to an infection
Give examples of ways the body prevents commensal bacteria from becoming pathogenic.

What type of culture is found on skin and soft tissue?
Gram +
Describe how blood cultures are run
Different bottles for collection (some are anaerobic and some aerobic)
Stored in conditions which promote growth (e.g 37 degress and bottles desgined to negate effects of antibiotics).
pH indicator on bottom of bottle changes colour as pH lowered from bacteria producing CO2
Takes about 18 hours
Describe antimicrobial susceptibility testing
After blood culture, collect sample and place on agar plates.
Place different ABs and see whether there is still growth or inhibition.
What are the complications of starting patients on antibiotics before sending off samples?
The antibiotics can interfere with the test results - potential for false negatives as the dose administered may not have a clinical effect but it might have an effect at the cellular level on the agar In meningitis or sepsis you administer anyway
Explain differences between gram positive and negative bacteria.
How does this affect gram staining?
Gram positive: Have a single cell membrane sorrounded by a peptidoglycan layer.
Gram negative: Have a cytoplasmic membrane and a lipopolysaccharacide membrane with a peptidoglycan layer between them
Gram positive appear purple due to the thick peptidoglycan wall which retains the dye.
Gram negative appears pink due to thick cell wall (double membrane with pep membrane in-between), causing dye to be incapable of staining so appears pink.

What is the most common type of bacteria?
How do they appear under a microscope?
Gram positive cocci such as:
Staphylococci
Appear purple after staining (gram positive), round in shape and clumped together like grapes.
Give an example of a test which can be used to determine the type of staphyloccoci in a sample.
Coagulase test: (Determines ability to coagulate)
+ indicates s.aureus

What is staphylococcus aureus and what conditions can it cause?
Coagulase postive staphylococci which are highly pathogenic and can lead to severe infections such as:
Skin infections
Endocarditis
Osteomyelitits
What kind of investigations may be performed?
culture e.g. agar or a broth
Serology
Molecular techniques
What can coagulase negative staphylococci cause?
It is less pathogenic in comparison to coagulase positive staphylococci (aka staph A).
They tend to live on the skin and have low pathogenic potential.
However if they breach the skin (e.g by infecting prosthetic material) they can cause infections such as:
Line infections
Pacemaker infections
Endocarditis
How do streptococci look under the microscope?
Form chains and appear purple in gram stain (gram positive)

What are the types of streptococci on blood agar?
What type of haemolysis can be displayed and state some common examples of streptococci in these groups and their clinical manifestations?
Alpha haemolytic streptococci: due to incomplete haemolysis it turns green.
e,g streptococcus pneumonia
Beta haemolytic streptococci: Due to complete haemolysis, clears the agar
Have two different groups:
Group A s.pyogenes (Cause pharyngitis, cellulitis, erysipelas)
Group B s.agalactiae (Causes neonatal sepsis and neonatal meningitis)
How do bacilli look under the microscope?
Appear pink as theyre gram negative and rod shaped

What are the possible causes of diarrhoea?
1)Bacteria:
E.g: Salmonella, Shigella, Campylobacter [Common in food poisoning], E. Coli, C. difficile, cholera.
2)Parasites:
E.g. Amoeba, Giardia, Cryptosporidium.
3) Viruses.
* N.B Must inform if patient has travel history so they can test for specifics such as cholera as it isnt normally tested*
When is c.difficile normally tested for?
Tested if someone has diarrhoea after being on AB usage.
AB can kill commensal bacteria and cause c.difficile to thrive in uncompetitive niche.
When are viruses normally detected for if someone is presenting with diarrhoea?
If someone comes in from nursing home or school and other individuals have been experiencing the same problems.
Explain the culturing proccess for bacteria that cause diarrhoea
Salmonella: XLD agar: the salmonella colonies are black due to hydrogen sulphide produced.
Campylobacter: 48hours to grow and can survive at 48 degrees so heat to kill other bacteria.
Vibrio cholerae: TCBS agar: cholera makes the agar turn green.